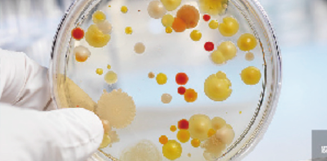
Image module

|
立式壓力蒸汽滅菌器(qì)MVS-83/83G型 号:MVS-83/83G 滅菌溫度: 115℃~135℃ 溶解溫度: 60℃~115℃ 保溫溫度: 45℃~60℃ 外(wài)部尺寸(WxDxH): 600×620×1005mm 內(nèi)部尺寸(WxDxH): Φ370×795mm 容積:75L 淨重:100kg 額定輸入功率:4200W 同系列産品:MVS-63/63G
收藏
産品編号 MVS-83/83G
商品說(shuō)明(míng)
商品參數(shù)
設計(jì)标準 內(nèi)部材料:S30408 設計(jì)壓力:0.3Mpa,安全閥排氣壓力:0.28Mpa 滅菌溫度:115~135℃,最小(xiǎo)分(fēn)度值0.1℃,溶解溫度:60~115℃,最小(xiǎo)分(fēn)度值0.1℃保溫溫度:45~60℃,最小(xiǎo)分(fēn)度值0.1℃ 嚴格遵循YY1007标準設計(jì),符合壓力容器(qì)GB150的(de)要(yào)求 采用(yòng)了(le)3mm厚的(de)GB/T24511标準的(de)不(bù)鏽鋼闆,提高(gā×o)了(le)安全性能(néng) ![]() 雙冷(lěng)卻風(fēng)扇 Dualcooling散熱(rè)系統,實現(xiàn)迅速降溫 在桶體(tǐ)左後和(hé)左前端設置了(le)兩個(gè)标配冷(lěng)卻風(fēng)扇,減少(shǎo)了(le)程序運行(xíng)冷(lěng)卻時(shí)間(jiān∏) 一(yī)鍵滅菌功能(néng) 隻需按下(xià)運行(xíng)健,直接按照(zhào)上(shàng)一(yī)次運行(xíng)的(de)參數(shù)開(kāi±)始程序,方便快(kuài)捷,減少(shǎo)重複操作(zuò),适用(yòng)于大(dà)批量重複≥操作(zuò) ![]() 海(hǎi)拔高(gāo)度對(duì)應 客戶可(kě)按照(zhào)實際使用(yòng)位置輸入海(hǎi)拔高(gāo)度,系統将自(zì)動計(jì)算(suàn)并匹配沸點等運行(xíng)參數(shù) 安全保障 低(dī)溫開(kāi)蓋,高(gāo)壓排氣,雙重幹燒保護,安全聯鎖機(jī)構 可(kě)選配HEPA過濾器(qì),對(duì)直徑大(dà)于0.2μm的(de)微(wēi)粒,過濾效果大(dà)于99.5% 故障自(zì)動診斷 中文(wén)故障顯示,原因一(yī)目了(le)然 工(gōng)作(zuò)模式 普通(tōng)滅菌 可(kě)對(duì)水(shuǐ)、培養基、試劑、液态食品等液體(tǐ)進行(xíng)滅菌處理(lǐ) ![]() 器(qì)械滅菌 燒瓶、燒杯、培養皿等能(néng)夠耐受、極速減壓的(de)器(qì)具進行(xíng)滅菌 ![]() 滅菌保溫 滅菌後可(kě)對(duì)物(wù)品進行(xíng)保溫 ![]() 溶解保溫 将培養基溶解後進行(xíng)保溫 ![]() |